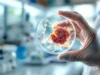
Nouveau traitement révolutionnaire pour le cancer du pancréas

Sandie, somatothérapeute : « J’utilise le toucher pour soulager les personnes atteintes de cancer »
Sandie Boulanger a changé de carrière pour devenir soignante. Aujourd’hui, elle accompagne des patients hospitalisés en cancérologie, soins palliatifs et gériatrie. Son objectif : soulager par le toucher et aider à libérer les émotions.
À l’occasion de la Journée mondiale de lutte contre le cancer, nous avons rencontré Sandie, qui pratique la somatothérapie. Elle explique que le toucher devient un outil précieux lorsque la communication verbale est difficile. Selon elle, « quand on ne parvient plus à communiquer ou à être en lien avec l’autre, le toucher devient fabuleux. »
Un parcours motivé par l’expérience personnelle
Tout a commencé pour Sandie en 2007. À cette époque, elle travaillait dans la publicité en tant que média planneuse. Sa fille, sans lien avec le cancer, se retrouve hospitalisée. Elle raconte : « Je me suis sentie impuissante. J’ai essayé de comprendre le fonctionnement non-verbal et d’accompagner au mieux mon enfant. Ces six mois difficiles m’ont amenée à réfléchir au sens de ma vie. »
Parallèlement, un ami âgé est en fin de vie à cause d’une tumeur au cerveau. Elle passe beaucoup de temps dans les hôpitaux. Elle découvre alors qu’elle se sent à l’aise dans cet environnement et souhaite apporter son soutien aux malades. Elle quitte son emploi et se forme à la relaxation, notamment la sophrologie, avant d’étudier la somatothérapie pendant deux ans.
Issue des courants psychanalytiques de Wilhelm Reich et Carl Rogers, cette thérapie psychocorporelle correspond à sa quête de lien. La pandémie de Covid a mis en lumière l’importance du toucher, qui permet de lever certains blocages, soulager la douleur et apaiser l’angoisse.
Le toucher, un outil pour gérer la douleur et les émotions
Après ses formations, Sandie débute comme somatothérapeute dans des associations en lien avec le cancer, puis à la clinique de l’Estrée à Saintains, en Seine-Saint-Denis. Elle précise que le toucher est peu utilisé dans les sociétés occidentales par rapport à d’autres cultures. Elle l’utilise pour soulager la douleur et calmer l’angoisse.
Elle masse notamment la poitrine et le ventre, zones où elle écoute la respiration et ressent les tensions musculaires. Ce contact crée un espace de sécurité, permettant aux patients de retrouver confiance, de parler et de libérer leurs émotions.
Reconnaissance et développement de la pratique
Convaincue des bienfaits de cette approche, Sandie l’a présentée à l’Assemblée nationale en 2024, devant le groupe d’études sur le cancer. Elle a été soutenue par la députée Sandrine Josso. Son projet a été bien accueilli, ce qui lui a permis d’obtenir un emploi à temps plein à l’hôpital d’Antony.
Elle intervient principalement dans les services de cancérologie et de soins palliatifs. Elle intervient aussi en chirurgie orthopédique et en gériatrie. Elle explique que les opérations peuvent provoquer une grande confusion, et que la somatothérapie aide à mieux gérer ces situations.
Un impact sur la réduction des médicaments et le bien-être
Sandie souligne que la somatothérapie contribue à calmer les patients pour améliorer leur récupération et diminuer la consommation d’anxiolytiques. Elle intervient également en réanimation, notamment auprès des patients intubés, et dans les phases de coma. Elle parle à leur corps, favorisant une perception de lien invisible à leur réveil.
Elle insiste aussi sur l’importance du toucher pour les personnes âgées, souvent peu ou plus jamais touchées autrement qu’en soins. Ce contact leur redonne de la joie et leur sentiment d’exister.
Sandie accompagne aussi les proches et les aidants. Elle leur offre un espace pour relâcher leurs émotions et acquérir de nouveaux outils pour faire face à des situations difficiles. Elle a créé une association, « Le cœur sur le soin », pour récolter des fonds et développer ces soins de support, en collaboration avec une oncologue et une cadre d’hôpital.
Une gestion émotionnelle face à la maladie
Confrontée régulièrement à la mort et à la souffrance, Sandie parvient à garder une certaine maîtrise émotionnelle. Elle explique qu’elle verbalise ses sentiments, ce qui l’aide à ne pas s’effondrer et à montrer l’importance de nommer ce que l’on ressent.
Passionnée par son métier, elle souhaite que la somatothérapie se démocratise davantage. Elle rappelle que dans notre pays, la prise en charge intégrative devient essentielle. Le lien de confiance, dit-elle, améliore le suivi des traitements, réduit l’anxiété et soulage la douleur. Pour elle, le contact est une philosophie de vie, permettant de donner autant que de recevoir.